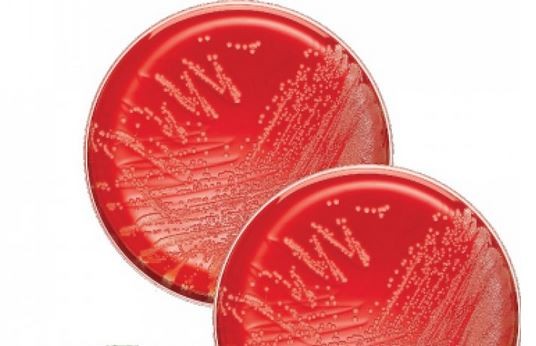

Anzucht
Für die mikrobiologische Diagnostik sind Keimzahlbestimmung und Erregeranzucht in Reinkultur essenziell.
Wir bieten Ihnen hierzu eine breite Auswahl an Fertignährböden, die Sie für die Anzucht und erste Differenzierung benötigen. Selektivmedien und Spezialnährböden für besonders anspruchsvoller Erreger, sowie Trockennährmedien und Medien für die Charakterisierung multiresistenter Erreger haben wir ebenfalls im Portfolio.
Die Anlage von Kulturen zeigen wir Ihnen in unserem Anwendungsvideo und unseren AUROSAN Hands-on Kursen zur Mikrobiologie von A-Z. Alle Termine und weitere Information zu unseren Fortbildungen finden Sie hier.
EUR 20,25 - EUR 21,59
zzgl. 19 % USt ggf. zzgl. Versandkosten
EUR 7,20 - EUR 7,70
zzgl. 19 % USt ggf. zzgl. Versandkosten
EUR 22,50 - EUR 24,30
zzgl. 19 % USt ggf. zzgl. Versandkosten
EUR 91,00
zzgl. 19 % USt ggf. zzgl. Versandkosten
EUR 60,00 - EUR 68,00
zzgl. 19 % USt ggf. zzgl. Versandkosten
EUR 12,50 - EUR 13,75
zzgl. 19 % USt ggf. zzgl. Versandkosten
EUR 29,45 - EUR 31,00
zzgl. 19 % USt ggf. zzgl. Versandkosten
EUR 249,00 - EUR 265,00
zzgl. 19 % USt ggf. zzgl. Versandkosten







_md5696_10000.png)